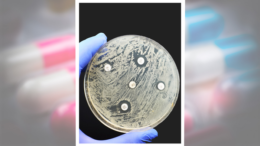

A Potential Gamechanger in Beating Antimicrobial Resistance
The COVID pandemic has revealed just how delicate our public health is in terms of overcoming infectious diseases and antimicrobial resistance. Over the last decade small proteins known as antimicrobial…